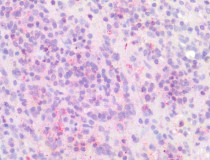

ARG44253
anti-IRF4 / MUM1 antibody
anti-IRF4 / MUM1 antibody for Flow cytometry,IHC-Formalin-fixed paraffin-embedded sections,Western blot and Human,Rat
概述
| 产品描述 | Goat Polyclonal antibody recognizes IRF4 / MUM1 |
|---|---|
| 反应物种 | Hu, Rat |
| 预测物种 | Ms, Cow, Dog |
| 应用 | FACS, IHC-P, WB |
| 特异性 | This antibody is expected to recognize both reported isoforms |
| 宿主 | Goat |
| 克隆 | Polyclonal |
| 同位型 | IgG |
| 靶点名称 | IRF4 / MUM1 |
| 抗原物种 | Human |
| 抗原 | Synthetic peptide around the internal region of Human IRF4 / MUM1 (DPQRQRKLITAHVEP) |
| 偶联标记 | Un-conjugated |
| 別名 | LSIRF; MUM1; Multiple myeloma oncogene 1; SHEP8; Interferon regulatory factor 4; NF-EM5; Lymphocyte-specific interferon regulatory factor; IRF-4 |
应用说明
| 应用建议 |
|
||||||||
|---|---|---|---|---|---|---|---|---|---|
| 应用说明 | * The dilutions indicate recommended starting dilutions and the optimal dilutions or concentrations should be determined by the scientist. |
属性
| 形式 | Liquid |
|---|---|
| 纯化 | Affinity purified |
| 缓冲液 | Tris saline (pH 7.3), 0.02% Sodium azide and 0.5% BSA. |
| 抗菌剂 | 0.02% Sodium azide |
| 稳定剂 | 0.5% BSA |
| 浓度 | 0.5 mg/ml |
| 存放说明 | For continuous use, store undiluted antibody at 2-8°C for up to a week. For long-term storage, aliquot and store at -20°C or below. Storage in frost free freezers is not recommended. Avoid repeated freeze/thaw cycles. Suggest spin the vial prior to opening. The antibody solution should be gently mixed before use. |
| 注意事项 | For laboratory research only, not for drug, diagnostic or other use. |
生物信息
| 数据库连接 | |
|---|---|
| 基因名称 | IRF4 |
| 全名 | interferon regulatory factor 4 |
| 背景介绍 | The protein encoded by this gene belongs to the IRF (interferon regulatory factor) family of transcription factors, characterized by an unique tryptophan pentad repeat DNA-binding domain. The IRFs are important in the regulation of interferons in response to infection by virus, and in the regulation of interferon-inducible genes. This family member is lymphocyte specific and negatively regulates Toll-like-receptor (TLR) signaling that is central to the activation of innate and adaptive immune systems. A chromosomal translocation involving this gene and the IgH locus, t(6;14)(p25;q32), may be a cause of multiple myeloma. Alternatively spliced transcript variants have been found for this gene. [provided by RefSeq, Aug 2010] |
| 生物功能 | Transcriptional activator. Binds to the interferon-stimulated response element (ISRE) of the MHC class I promoter. Binds the immunoglobulin lambda light chain enhancer, together with PU.1. Probably plays a role in ISRE-targeted signal transduction mechanisms specific to lymphoid cells. Involved in CD8(+) dendritic cell differentiation by forming a complex with the BATF-JUNB heterodimer in immune cells, leading to recognition of AICE sequence (5'-TGAnTCA/GAAA-3'), an immune-specific regulatory element, followed by cooperative binding of BATF and IRF4 and activation of genes (By similarity). [UniProt] |
| 细胞定位 | Nucleus. [UniProt] |
| 预测分子量 | 51 kDa |
| 翻译后修饰 | Phosphorylation by ROCK2 regulates IL-17 and IL-21 production. [UniProt] |
检测图片 (4) Click the Picture to Zoom In
-
ARG44253 anti-IRF4 / MUM1 antibody IHC-P image
Immunohistochemistry: Human Spleen stained with ARG44253 anti-IRF4 / MUM1 antibody at 5µg/ml dilution.
-
ARG44253 anti-IRF4 / MUM1 antibody WB image
Western blot: Human Spleen stained with ARG44253 anti-IRF4 / MUM1 antibody at 0.3µg/ml dilution.
-
ARG44253 anti-IRF4 / MUM1 antibody FACS image
Flow Cytometry: A431 stained with ARG44253 anti-IRF4 / MUM1 antibody at 10µg/ml dilution.
-
ARG44253 anti-IRF4 / MUM1 antibody WB image
Western blot: Mouse Spleen stained with ARG44253 anti-IRF4 / MUM1 antibody at 0.3µg/ml dilution.